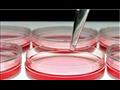

التهاب دواعم السن.. ما أهمية الاختبارات الميكروبيولوجية؟
كتب : مصراوي
-
عرض 3 صورة
-
عرض 3 صورة

-
عرض 3 صورة

د ب أ-
يطلب بعض أطباء الأسنان إجراء اختبارات ميكروبيولوجية للمساعدة في التعرف على سبب التهاب دواعم السن ومن ثم تحديد العلاج.
فما مدى أهمية هذه الاختبارات؟
وفي مقابلة مع البروفيسور بيتر آيكهولتس، يشرح طبيب الأسنان الألماني سبب عدم فائدة هذه الاختبارات في معظم الحالات للعلاج.
سؤال: يقوم بعض أطباء الأسنان بإجراء اختبار ميكروبيولوجي لأنواع معينة من البكتيريا المسببة لالتهاب دواعم السن، فما الفائدة منه؟
جواب: التهاب دواعم السن لا ينتج فقط نتيجة عدوى بأنواع قليلة من البكتيريا، بل ينجم أيضا عن مناعة المريض ضد الإصابة باللويحات البكتيرية، كما أن الاختبارات الخاصة بأنواع قليلة من البكتيريا لا تؤثر على أي قرار علاجي ولا تقدم أي معلومات مفيدة بخلاف التشخيص السريري. ويعني هذا أنها لا تفيد في اختيار المضادات الحيوية للعلاج.
سؤال: هل هناك حالات يكون فيها الاختبار مفيدا؟
جواب: نعم، ولكن في حالات استثنائية نادرة فقط، على سبيل المثال إذا كان العلاج ببساطة لم ينجح، مع التأكد من أن كل شيء قد تم بشكل صحيح مثل تنظيف الأسنان بشكل صحيح، وتنظيف جيوب اللثة جيدا، ولا توجد أمراض عامة تضعف مناعة الجسم ضد العدوى أو إذا تم الاشتباه في أن نوعا فرعيا محددا جدا من البكتيريا هو سبب التهاب دواعم السن.
سؤال: إذا كانت مثل هذه الاختبارات لا تؤثر على العلاج في معظم الحالات، فلماذا يقوم بها بعض الأطباء؟
جواب: في البداية يعتمد المريض على خبرة طبيب الأسنان، الذي يذهب إليه، لكن يتعين على المريض سؤال الطبيب حول الفرق، الذي يحدثه الاختبار من حيث قرار العلاج. ويجب أن يكون طبيب الأسنان قادرا على الإجابة عن هذا السؤال، مع العلم بأن الاختبار، الذي لا يعتمد عليه أي شيء علاجي لا فائدة منه.